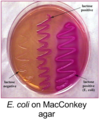

How big is a bacterial chromosome? How many genes?
500 - 6000 kb
How big is a bacterial plasmid?
1.5 - 300 kb
What are the differences between a bacterial chromosome and a plasmid?
- Chromosome carries all essential genes
- Plasmid contains genes that are conditional
- Plasmids replicate independently
Are genes for antibiotic resistance, virulence, metabolic pathways, bacteriocins, and transfer genes located on the bacterial chromosome or plasmid?
Plasmid
How long is an E. coli chromosome?
~1 mm
Compacted to 10% of the cell’s volume

What genes does a conjugative plasmid carry?
Genes necessary for transfer of the plasmid to another cell
What genes do dissimilation plasmids carry?
Enzymes for catabolism of unusual compounds such as:
- Toluene
- Camphor
- Petroleum hydrocarbons
In what organism are dissimilation plasmids most prevalent?
- Pseudomonas*
- Agrobacterium tumefaciens*
What genes do R factors/plasmids carry?
Resistance to antibiotics, bacteriophages or heavy metals

What genes do virulence plasmids carry?
Proteins that enchance pathogenicity:
- attachment to host cell
- Toxins, neurotoxins, shiga toxin
What genes do bacteriocin plasmids carry?
Toxic proteins that kill other bacteria
Ex: Staphylococcus epidermis produces satphylcoccin
What bacteriocin does Lactococcus lactis produce?
Nisin
What bacteriocin does E. coli produce?
Colicin
Genes are assigned a 3-letter designation based on either ______ (4)
- Pathway they are involved in
- Cell strucuture
- Cell function
- Mutant phenotype
Different geenes affecting the same pathway are distinguished by ______
Capital letters
Ex: fadA, fad B, fadD
Genes not listed in a genotypes are assumed _____
Wildtype
Ex E. coli genotypes: MC1061 araD139 Δ(araA-leu)7696 galE15 galK16 lacX74 rpsL50 hsdR2 argF2
Gene names should always be written in _____ and _____
- lower case
- italicized
Explain how they name phenotypic designations
- 3-letter symbols
- Not italicized
- First letter is capitalized
“Bio-“ describes what phenotype?
Requires biotin added as a supplement to minimal medium
“Arg-” describes what phenotype?
Requires arginine added as a supplement to minimal medium
“Met-” describes what phenotype?
Requires methionine added as a supplement to minimal medium
“Lac-” describes what phenotype?
Cannot utilize lactoase as a carbon source
“Gal-” describes what phenotype?
Cannot utilize galactose as a carbon source
“Strr” describes what phenotype?
Resistant to streptomycin